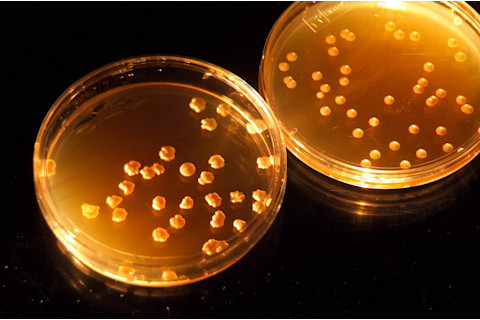
astrobiology_2-1024x678.jpg

(图片来源:NASA) 未来宇航员们,别担心,转基因生物很可能会陪伴你们进行深空探险。科学家们希望通过基因工程改造生物,使其能够在地球以外生存,并在飞船和其他行星上完成一些繁重的工作。这一研究领域被称为“太空合成生物学”。而这一基因研究的新前沿可能是开启最终边疆的关键。
生物学即技术
合成生物学,总的来说,是指通过改变基因来赋予生物体改变的或甚至新颖的特征的工作。太空合成生物学家通过基因改造生物,使它们更适合太空——例如,抵抗辐射或高温——并使它们对太空任务有用——比如将火星的泥土变成混凝土。这听起来有些“异想天开”,但微生物已经使我们的地球宜居且舒适。“我们呼吸的氧气是生物产生的,”NASA艾姆斯研究中心合成生物学项目负责人Lynn Rothschild说。“我穿的棉花也是生物生产的。”她解释说,我们不会把羊带到太空任务中,但我们可以把制造氧气和棉花植物的能力,植入到更便携的生命体(如酵母)的DNA中。“开始把生物学看作一项技术,”她说,这是一项“基因硬件故事”,可以渗透到太空任务的方方面面。
在艾姆斯研究中心实验室,一个装有样本的培养皿在LED灯下被照亮。(图片来源:NASA) Rothschild指导着斯坦福-布朗大学在国际基因工程机器大赛中的团队,她的团队已经完成了许多项目,包括用 DNA 作为模板制造导线;创造了一个可生物降解的无人机;并将来自极端细菌的基因插入到大肠杆菌中,创造出能够抵抗极端 pH 值、温度和干燥的混合生物体。他们称之为“地狱细胞”。根据伯克利加州定量生物科学研究所领导的一项11 月的报告,这种生物基技术与“非生命”系统相比,所需的质量要少 26-85%。例如,一艘宇宙飞船可以像阿波罗任务载着飞船登陆月球一样,载着一个栖息地到火星,但没有人想住在铁罐头里,而且那个铁罐头也很重。“想象一下地球早期长途旅行的类比,”Rothschild说,就像去北美的朝圣者。“他们没有带房子。他们学会了就地取材。”
太空中的微生物工作
未来的宇航员将不得不依靠不适宜居住的土地和没有土地的飞船生存。Menezes 的报告为这些宇航员制定了一个计划,提出了研究可能的发展方向。例如,我们在地球上用于堆肥和废物处理的微生物会产生一氧化二氮,这是一种飞船的推进剂。我们可以通过基因工程改造这些微生物,让它们在太空中执行任务,但对氧气的需求不同,反应能力更快,但基本化学原理相同。因此,仅仅通过排泄和制造垃圾,宇航员就可以为燃料创造原材料。一旦这些制造垃圾的殖民者到达火星,他们就可以使用携带的微生物来开采建造新家园的材料。能产生酸的微生物可以溶解环绕金属的火星岩石,只留下“资源”。或者我们可以改造微生物来溶解资源本身,使其流出,然后可以重新组合成殖民地前哨站。火星上的建筑公司可以利用“风化层”(表面材料),并使用天然胶水将其粘合在一起,例如贻贝足蛋白(为在火星上达到最佳性能而进行了工程化改造)。科学家们还可以制造吞噬风化层并吐出钙或铁以制造“生物水泥”的微生物。剩余物! 废物处理、制造和建筑都会留下有用的副产品,如甲烷,它可以帮助为殖民地提供电力。虽然通电的前哨站不会有很多奢侈品。但科学家们必须确保宇航员的基本需求:空气、水和食物,无限期地供应。

太空合成生物学的六大挑战。(图片来源:Hugo Teixeira via Royal Society Interface) Menezes 建议开发适合太空的微生物,将废水处理的副产品转化为食物(美味!)。虽然食物不必是米其林星级品质,但它必须符合“营养丰富的生物质,可以补充宇航员的干粮,并且在风味和质地上具有多功能性”。如果飞船或殖民地的墙壁是活的(这并不可怕),微生物就可以将二氧化碳升级为氧气,并且——额外的好处!——可以保护宇航员免受辐射。辐射不仅会用致癌突变来破坏我们的 DNA,还会加速药物的过期。
药物柜的工程
人们在太空中仍然会生病,所以合成生物学家也在研究基于生物的医疗保健。微生物和植物可以被工程化以制造药物,并使微生物组——与我们每个人共生的社区——恢复正常。“如果宇航员能在藻类中种植药物,我认为那将是超级酷的,”NASA 艾姆斯研究中心的太空合成生物学家 Josiah Zayner 说,他不是该论文的作者,“但我认为这需要大量的金钱和资源才能实现。”但 Menezes 猜想,如果飞船或殖民地更加“活着”,充满了生物传感器和生物控制系统呢?如果听起来太像太空堡垒卡拉狄加中的赛昂人让你感到不安,Zayner 说,暂时不用担心。“老实说,我认为这只是他们‘异想天开’的想法,”他说。“他们描述的系统实际上还没有被发明出来。当我听到‘混合机器人版本的杀死肿瘤的细菌’时,我就已经听不下去了。”我也是。但 Menezes 反驳说,这并非那么异想天开。“太空控制论的宏大挑战本质上要求将控制系统的理念应用到生物系统中,”他说——这与将人类送上月球并让“好奇号”漫游火星的控制系统是相同的。但这是通过生物学实现的。他继续说,将两者与技术相结合将“需要一些时间”,但“完整且经过测试的太空合成生物学系统应该在几十年内准备就绪,如果不能赶上第一次美国载人火星探测,肯定能在第二次或第三次探测时做好准备。”

火星居住区被土壤覆盖以保护乘员免受太阳辐射的艺术渲染图。(图片来源:NASA) 但即使是拥有生命墙壁、藻类花园和营养丰富的生物质的赛博飞船或殖民地,也不足以实现一个自给自足、长寿命的火星栖息地。要实现这一点,我们要么需要将火星变成一个像地球一样的行星——要么我们需要在火星上建造一个微型地球。要“地球化”一个行星,就是把它变成地球。但“类地化”是更现实的一步——将一个更小、更封闭的空间变成一个自给自足、对人类友好的地方。就火星而言,这将是一个可居住的区域,周围是可怕的即时致命的荒漠。科学家们必须工程化整个生态系统,以创造宇航员生存、饮用、呼吸、保持健康、理智和高效所需的条件。同时要回收他们的废物,并使他们的环境与上述可怕的即时致命的荒漠隔离开——使用微生物。“我认为这应该是载人火星任务之前的头号研究目标,”Zayner 说。
现实检验
Menezes 的报告正是着眼于载人火星任务。“所有这一切都是从在未来 20 年内登陆火星的视角出发,而不是从合成生物学在 20 年后会做什么的视角出发,”Zayner 说,“因为这极难计划。”而且这取决于是否有足够的资金和人员来完成这项工作。Zayner 还警告说,任何基于生命的太空系统都需要在出现在载人舱或红色星球的殖民地之前数年进行测试和建造。因此,火星任务发射时存在的尖端技术可能不会出现在这次火星旅行中——经过充分验证的、较旧的技术很可能会被采用。这在任何太空任务中都是如此,工程师们通常会在发射前很多年就设计并开始建造。但 Menezes 表示,原型和实际应用之间的差距正在缩小,这在很大程度上是因为太空行业不再完全由政府运营。“就在昨天,我得知有一个项目在六个月内从概念构想到实际太空部署,”他说。“虽然这个时间表目前并不常见,但随着商业太空事业的兴起,现在可以与商业伙伴合作,在太空中快速测试和表征有益的想法。”但飞船带着充满希望的技术发射后,火星上也可能出现问题。我们可能用于建筑的风化层含有高氯酸盐,这是一种对人类有毒的盐。有毒的砖块无法建造理想的殖民地。“高氯酸盐目前当然是个问题,”Menezes 说。但我们可以设法解决这些问题,并且在我们最初利用火星资源的过程中,可以使用火星的空气而不是其土地。“例如,火星大气中有 95% 是二氧化碳。二氧化碳将是微生物的主要碳源。”虽然创造我们自己独特的太空生物学听起来像是科幻小说,但非虚构科学家也在努力将这些概念变为现实。为了工程化在其他行星上有用的生物,他们首先关注我们自己的世界及其生物学。通过改变和组织这些生物“野兽”以形成有用的太空系统,科学家们也将学会如何让地球上的生活变得更好。“太空合成生物学的可能性是无穷无尽的,但其中的每一个都对地球具有巨大的重要性,”Menezes 说。用于解决太空医学、食品和二氧化碳问题的合成生物学解决方案,可以解决地球上类似的问题:个性化医疗、满足不断增长人口的农业,以及修复我们充满二氧化碳的大气层。而类地化空间虽然为宇航员提供了安全的睡眠场所,但这些技术也可以帮助我们学会如何在地球上可持续地生活。火星殖民地将是最终的零废物绿色空间,其理念应该得到所有地球人的支持。“我发现,进行‘遥远的太空活动’同时又是地球上的优先事项,这种观念非常吸引人且引人注目,”Menezes 说。














